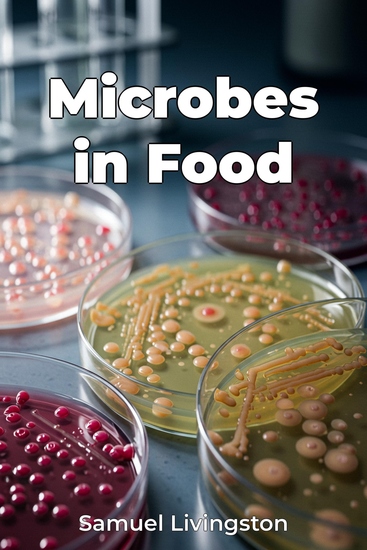

Microbes in Food
Samuel Livingston
Übersetzer A AI
Verlag: Publifye
Beschreibung
"Microbes in Food" unveils the hidden world of microorganisms and their pivotal role in creating many of our favorite foods. From the tangy zest of yogurt to the complex flavors of aged cheese, microbes are not just present but essential. The book explores how these tiny organisms, including bacteria and fungi, transform raw ingredients through processes like fermentation, impacting flavor, texture, and preservation. It's intriguing to discover that some microbial processes, developed centuries ago, are still vital in modern food production, illustrating the enduring power of these natural transformations. The book approaches this topic by first introducing the basic concepts of microbial metabolism and genetics relevant to food. It then examines their application in creating common food items like dairy products and fermented vegetables. Readers will gain insights into the scientific principles that govern microbial activity, learning how controlling these processes leads to consistent, high-quality food. The book progresses from the history of microbial food processing, through modern applications, and finally towards future implications, covering food safety, sustainability, and novel food sources.














